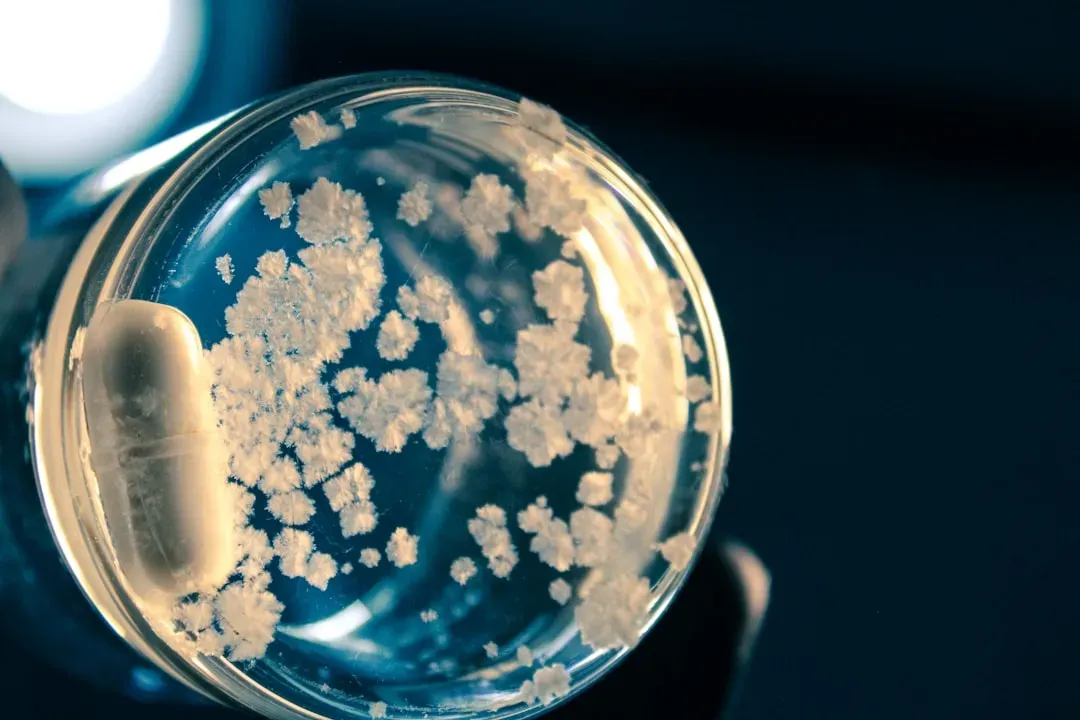
Antarctic Microbes: Life at the Edge of Nothing (Image Credits: Unsplash)

Somewhere on this planet, right now, there are living beings that were already ancient when the pyramids were new. They’ve watched ice ages come and go, seen oceans rise and fall, and quietly survived while entire civilizations appeared and vanished. These organisms don’t just stretch our sense of time; they shatter it, forcing us to rethink what it really means to be “old” and “alive.”
When you start looking into the world’s oldest life-forms, things get weird fast. Trees that clone themselves into forests, jellyfish that can rewind their own life cycle, mushrooms that are really sprawling underground empires – this is nature operating on time frames our brains aren’t built to grasp. And yet, hidden in their strange biology are clues about resilience, adaptation, and maybe even how we might live longer and healthier lives ourselves.
The Methuselah Trees: Ancient Bristlecones of the High Sierra

High in the White Mountains of California, twisted, ghostly bristlecone pines have been standing for thousands of years, some older than recorded history. Individual trees have been dated to more than four and a half millennia, meaning they were alive well before the dawn of classical civilizations. Their trunks look dead and half fossilized, yet a thin strip of living tissue just beneath the bark keeps them going year after year. They thrive where almost nothing else can survive: thin soil, brutal cold, fierce winds.
Their secret is a mix of slow growth, extreme toughness, and ruthless efficiency. Because they grow so slowly, their wood becomes incredibly dense and resistant to decay, like nature’s own reinforced concrete. Their needles can last for decades, sparing them the energy of constant renewal. I remember standing near one of these bristlecones once, feeling bizarrely small, like I was talking to a time traveler that quietly ignored me. They’re a reminder that sometimes the path to a long life isn’t speed and abundance, but restraint and patience.
Pando: The Giant Clonal Aspen That’s Really One Immense Organism

At first glance, Pando in Utah just looks like a beautiful aspen grove, shimmering with those familiar white trunks and fluttering leaves. But genetically, it’s actually one single organism, a massive clonal colony connected by an underground root system. Each “tree” you see above ground is like a finger on the same unseen hand below. Scientists estimate that Pando has been around for thousands, and possibly tens of thousands, of years, quietly regenerating itself over and over.
Pando’s strategy for longevity is clever: it doesn’t cling to any one trunk. When one stem dies, new ones sprout from the shared root system, like a living relay race passing the baton across centuries. That underground network acts as its true body, storing energy, sharing resources, and coordinating growth. At the same time, Pando is under pressure from human activity and grazing animals, and parts of it are struggling to regenerate. It’s a strange feeling knowing that something this ancient, once so resilient, might depend on our choices in the next few decades.
The Immortal Jellyfish: Turritopsis and the Art of Aging Backwards

In the warm waters of the world’s oceans, a tiny jellyfish only a few millimeters across may hold one of the wildest tricks in nature. Turritopsis dohrnii, often nicknamed the “immortal jellyfish,” can, under stress or injury, revert from its adult form back to an earlier life stage. It’s like a butterfly turning back into a caterpillar, and then growing up again, theoretically capable of repeating this cycle again and again.
This process, called transdifferentiation, allows its cells to essentially reset and become different types of cells, rebuilding its body from the ground up. In theory, that means no built-in expiration date, only external dangers like predators or disease. Researchers are fascinated by how this radical cellular flexibility might inform our understanding of aging, regeneration, and even human medicine. The jellyfish isn’t some magical cure-all, but it’s a living hint that aging might not be as one-directional as we once believed.
Mats of Time: Stromatolites and Microbial Cities Older Than Animals

If you walked along certain shallow coastlines in places like Western Australia, you might see what look like dull, lumpy rocks sticking out of the water. Those structures, called stromatolites, are actually built by layers of tiny microbes, mostly cyanobacteria, piling up over time. Similar communities have existed in some form for billions of years, making them among the oldest living systems on Earth. Long before trees, fish, or even insects, these microbial mats were shaping the planet’s atmosphere.
Cyanobacteria in ancient stromatolites pumped oxygen into the oceans and then the air, helping drive one of the most dramatic shifts in Earth’s history. Modern stromatolites are like living echoes of that era, slow-growing but incredibly persistent. They remind us that “oldest life” doesn’t always mean a single individual with a birth date, but ongoing communities and lineages that have persisted almost unimaginably long. In a way, they’re like ancient cities that never stopped being inhabited, just rebuilt layer by layer over geological time.
The Great Basin’s Ancient Shrubs and Desert Survivors

It’s easy to overlook low, scrubby plants compared to towering redwoods or gnarled pines, but some desert shrubs have lifespans that quietly rival the giants. In the Great Basin region of the United States, for example, certain creosote bush clonal rings are thought to be thousands of years old. Each ring is formed as new stems grow around the dying center, slowly expanding outward like a living ripple frozen in place. Above ground, the stems may only be a few decades old, but the genetic individual – the clone – has been around far longer.
Desert longevity hinges on endurance and extreme water thrift. These shrubs have deep or wide-reaching root systems, waxy leaves, and the ability to shut down or slow their metabolism when conditions get harsh. Their growth strategy feels almost philosophical: do just enough, waste nothing, outlast everything. Standing near an old creosote ring, surrounded by empty, sun-blasted land, it can hit you that resilience isn’t loud or flashy. It’s quiet, repetitive survival over ridiculous stretches of time.
Fungi Giants: The Hidden Ages of Underground Mycelium Networks

When most people think of fungi, they picture mushrooms on a log or in a salad, but those are just the fruiting bodies – the surface decorations of a much larger hidden organism. Beneath the soil, webs of threadlike mycelium can spread for huge distances, and in some cases, they form what may be among the largest and oldest living things on Earth. In certain forests, a single fungal individual can occupy many hectares, quietly extending and renewing itself over centuries.
These fungal networks not only feed on organic matter but can also link with tree roots, forming vast underground exchange systems sometimes called mycorrhizal networks. Through these connections, fungi and plants trade nutrients and water, and in some cases help each other survive stress or disease. Long-lived fungi succeed because they are adaptable, decentralized, and able to shift their activity based on resources, like a slow-motion internet built of living threads. The idea that an entire forest might partially share one ancient fungal “partner” changes how we think about individuality and age.
Antarctic Microbes: Life at the Edge of Nothing
In the exposed, frozen deserts of Antarctica, you might assume nothing lives at all, yet that’s far from true. Microbes tucked into tiny cracks in rocks, or living in subglacial lakes sealed off by ice for millennia, have adapted to conditions that would kill most known organisms. Some microbial communities there survive on minimal energy, enduring extreme cold, intense radiation, and very little liquid water. Their metabolic rates are so low that individual cells may persist for extraordinarily long spans of time without dividing often.
What makes these Antarctic microbes fascinating is how close they seem to the boundary between life and non-life while still remaining active, just incredibly slowly. Studying them offers clues not only about longevity but also about where life might exist beyond Earth, on icy moons or Mars-like planets. They show that long life doesn’t always mean constant growth or change; sometimes it means pausing on a timescale that feels almost geological. It’s like they have stretched out a single “moment” of existence into centuries.
What These Elders of the Earth Teach Us About Time and Survival

Looking across all these organisms – trees, jellyfish, microbes, fungi – one theme stands out: there’s no single formula for longevity. Some slow everything down, others regenerate constantly, some spread out underground, and others form communities that outlive any one member. Longevity, in nature, seems less about individual glory and more about strategies that reduce risk, avoid waste, and stay flexible when conditions change. It’s a lesson that feels surprisingly relevant in a world moving faster than ever.
There’s also a humbling emotional punch to realizing you share a planet with beings that may outlast your entire culture, maybe even your species. Standing under an ancient tree or imagining an invisible fungal network beneath your feet can shift your sense of scale in a way few things can. These oldest living organisms are not just curiosities; they are living libraries of survival strategies written over deep time. They quietly ask us, without words, a simple question: in the long run, are we trying to live big, or are we trying to live long?




